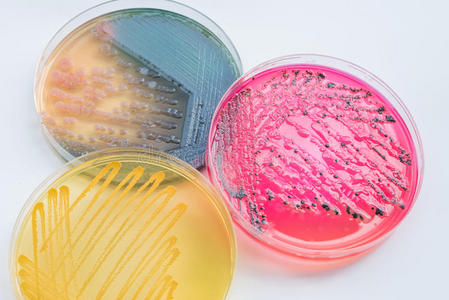
琼脂培养基图片-琼脂培养基素材-琼脂培养基插画-摄图新视界

培养基图片

生产液体菌种需要准备哪些东西?它的接种与培养应该怎么做?
图片尺寸634x430
大豆酪蛋白琼脂胰酪大豆胨琼脂培养基tsa培养皿平皿平板 90mm无菌-阿
图片尺寸800x800
【双歧杆菌培养基】双歧杆菌培养基品牌,价格 - 阿里巴巴
图片尺寸300x225
关于微生物实验室干粉培养基的管理及保存-帖子-标准物质网
图片尺寸1080x1071
培养基照片,不断更新中………… - 第2页 - 食品微生物检测 - 食品论
图片尺寸3264x2448
黑色素细胞那些事,你了解吗?_化工仪器网
图片尺寸2848x1728
无胆甾原体价格_无胆甾原体厂家_仪器信息网
图片尺寸496x333
鸭舍里细菌太多了! - 常维山(微生物/实验室诊断) - 鸡病专业网论坛
图片尺寸2560x1440
默克密理_厂商报价✔仪器信息网
图片尺寸591x600
细菌总数显色培养基 -微生物图片-青岛海博生物
图片尺寸700x1025
培养基照片,不断更新中………… - 食品微生物检测 - 食品论坛 - powe
图片尺寸2816x2112
志贺氏菌显色培养基_厂商报价✔仪器信息网
图片尺寸5760x3840
大肠杆菌o157显色培养基平板 大肠杆菌o157显色琼脂培养基_厂家_报价_
图片尺寸1920x1440
2216e液体培养基 2216e液体培养基@技术说明_产品说明_技术文章_卡迈
图片尺寸1000x1263
江苏齐氏生物科技有限公司_产品目录_产品价格_第1页
图片尺寸300x300
实验室培养皿中的培养基
图片尺寸1200x795
琼脂培养基图片-琼脂培养基素材-琼脂培养基插画-摄图新视界
图片尺寸449x300
煌绿乳糖胆盐肉汤bglb瓶装颗粒培养基品牌:博湖进口,国产-盖德化工网
图片尺寸980x932
琼脂培养基图片-琼脂培养基素材-琼脂培养基插画-摄图新视界
图片尺寸449x300
沙门氏菌检验注意事项:生化鉴定三糖铁琼脂,培养基技术资料
图片尺寸805x2083